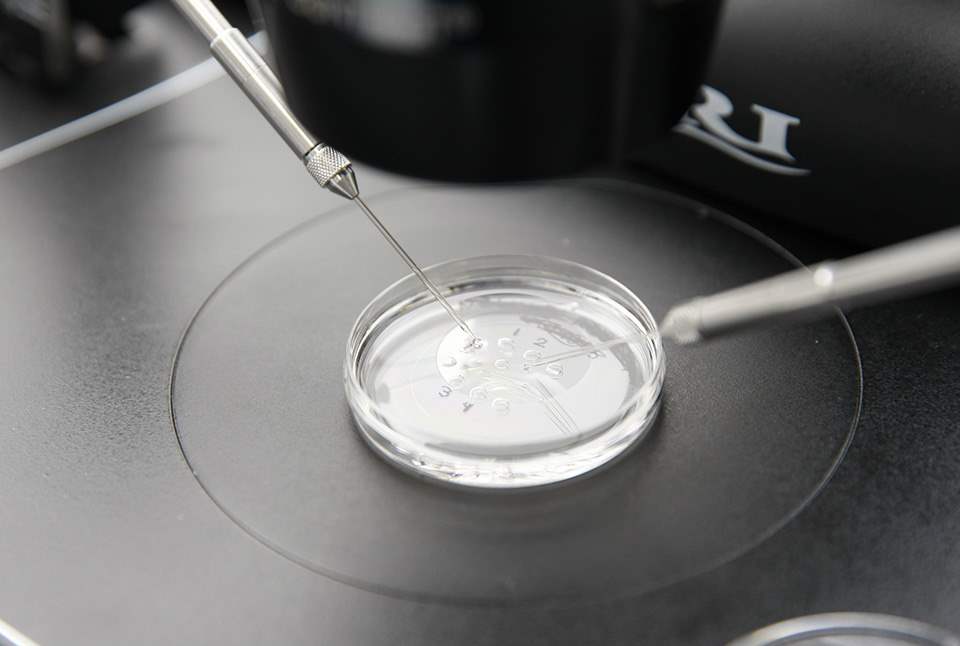
Calls for national tariff on IVF

CAPPING the total cost of an IVF cycle could help more women have access to fertility treatments, says a leading expert.
Dr Geeta Nargund, Medical Director at Create Health, believes setting a national tariff for all IVF treatments would encourage best practice amongst both public and private sectors, as well as reduce costs.
Following the recent NICE guidelines, which recommend that women aged 40-42 and same sex couples should now qualify for IVF on the NHS, critics have hit out at the cost of the new measures at a time of public sector budget cuts.
Dr Nargund, who welcomed last week’s recommendations, comments: “The recent NICE guidelines are certainly a step in the right direction but we have to be realistic in how this is going to be implemented – many women could still miss out on treatment purely because their local primary care groups cannot pay for it.
“Setting a national tariff would increase people’s chances of accessing IVF treatments in their local areas, giving more tax-paying citizens the right to try for a family if they cannot do so naturally.”
Capping the total cost of IVF treatment per cycle at a set rate would also encourage NHS and private clinics to use less drug dosages and reduce costs of additional blood tests that are an expensive part of the IVF cycle.
Nargund continues: “I have long been an advocate of mild stimulation IVF over conventional IVF, which involves a lower dosage of drugs – it means safer treatment with reduced risk of OHSS and fewer side-effects as well as lower cost. We need to reduce complications such as ovarian hyperstimulation syndrome (OHSS), which is a serious health risk for women, and also reduce incidence of multiple pregnancies. If we implement elective single embryo transfer for younger women and use mild IVF with fewer drugs, we reduce costs of treatment and those associated with treating complications."